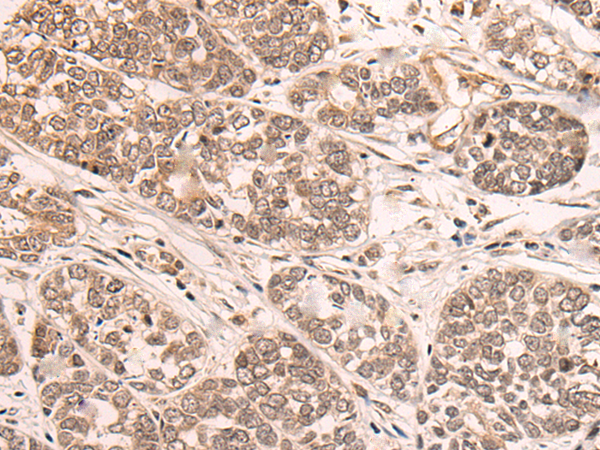

-
分类: 科研抗体货号: P13003别名: EA5; EJM; CAB4; EIG9; EJM4; EJM6; CACNLB4应用: IHC反应种属: Human, Mouse
-
分类: 科研抗体货号: P12988别名: HSM1; HSS1; C19orf63应用: WB,IHC反应种属: Human, Mouse, Rat
-
分类: 科研抗体货号: P12993别名: hLDAH; C2orf43应用: WB,IHC反应种属: Human
-
分类: 科研抗体货号: P13002别名: CACNA2D应用: IHC反应种属: Human, Mouse, Rat
-
分类: 科研抗体货号: P12987别名: RMP; URI; NNX3; C19orf2; PPP1R19应用: WB,IHC反应种属: Human, Mouse
-
分类: 科研抗体货号: P12992别名: SOGA; KIAA0889; C20orf117应用: IHC反应种属: Human
-
分类: 科研抗体货号: P13001别名: ECA6; EIG6; Cav3.2; CACNA1HB应用: IHC反应种属: Human, Mouse
-
分类: 科研抗体货号: P12986别名: C18orf26应用: IHC反应种属: Human
-
分类: 科研抗体货号: P13021别名: CAS4; HEFL; HEPL; C20orf32应用: IHC反应种属: Human
-
分类: 科研抗体货号: P13000别名: BIII; CACNN; DYT23; Cav2.2; CACNL1A5应用: IHC反应种属: Human, Mouse, Rat

鄂公网安备42018502007531号
鄂公网安备42018502007531号

